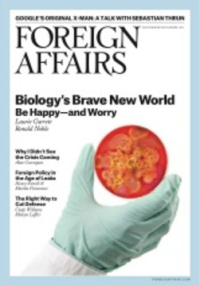

Foreign Affairs November/December 2013, Volume 92 Number 6
Comments
1. Google's X-Man: a Conversation with Sebastian Thrun.
2. A Kinder, Gentler Immigration Policy: Forget Comprehensive Reform-Let the States Compete--Jagdish Bhagwati and Francisco Rivera-Batiz.
3. Left Out: How Europe's Social Democrats Can Fight Back--Henning Meyer.
4. The End of Hypocrisy: American Foreign Policy in the Age of Leaks--Henry Farrell and Martha Finnemore.
Essays
1. Biology's Brave New World: the Promise and Perils of the Synbio Revolution--Laurie Garrett.
2. Keeping Science in the Right Hands: Policing the New Biological Frontier--Ronald K. Noble.
3. Accepting Austerity: the Right Way to Cut Defense--Cindy Williams.
4. Defense on a Diet: How Budget Crises Have Improved U.S. Strategy--Melvyn P. Leffler.
5. Cyberwar and Peace: Hacking Can Reduce Real-World Violence--Thomas Rid.
6. Never Saw it Coming: Why the Financial Crisis Took Economists by Surprise--Alan Greenspan.
7. Why Banking Systems Succeed-and Fail: the Politics Behind Financial Institutions--Charles W. Calomiris and Stephen H. Haber.
8. Bridge to Somewhere: Helping U.S. Companies Tap the Global Infrastructure Market--Jose W. Fernandez.
9. The Devolution of the Seas: the Consequences of Oceanic Destruction--Alan B. Sielen.
Review & Responses
1. The Spoils of War: the Horrors and Hopes of 1945--Max Hastings.
2. India and Ideology: Why Western Thinkers Struggle with the Subcontinent--Pankaj Mishra.
3. In Search of the Real China: Outsiders Still See what They Want to See--John Pomfret.
4. Border Battle: the Ugly Legacy of the Mexican-American War--Enrique Krauze.
5. The Case for International Law: a Response to "The War of Law"--Harold Hongju Koh and Michael Doyle.
6. How to Copy Right: is Piracy Productive?--Steven Tepp, Kal Raustiala and Christopher Sprigman.
1. Google's X-Man: a Conversation with Sebastian Thrun.
2. A Kinder, Gentler Immigration Policy: Forget Comprehensive Reform-Let the States Compete--Jagdish Bhagwati and Francisco Rivera-Batiz.
3. Left Out: How Europe's Social Democrats Can Fight Back--Henning Meyer.
4. The End of Hypocrisy: American Foreign Policy in the Age of Leaks--Henry Farrell and Martha Finnemore.
Essays
1. Biology's Brave New World: the Promise and Perils of the Synbio Revolution--Laurie Garrett.
2. Keeping Science in the Right Hands: Policing the New Biological Frontier--Ronald K. Noble.
3. Accepting Austerity: the Right Way to Cut Defense--Cindy Williams.
4. Defense on a Diet: How Budget Crises Have Improved U.S. Strategy--Melvyn P. Leffler.
5. Cyberwar and Peace: Hacking Can Reduce Real-World Violence--Thomas Rid.
6. Never Saw it Coming: Why the Financial Crisis Took Economists by Surprise--Alan Greenspan.
7. Why Banking Systems Succeed-and Fail: the Politics Behind Financial Institutions--Charles W. Calomiris and Stephen H. Haber.
8. Bridge to Somewhere: Helping U.S. Companies Tap the Global Infrastructure Market--Jose W. Fernandez.
9. The Devolution of the Seas: the Consequences of Oceanic Destruction--Alan B. Sielen.
Review & Responses
1. The Spoils of War: the Horrors and Hopes of 1945--Max Hastings.
2. India and Ideology: Why Western Thinkers Struggle with the Subcontinent--Pankaj Mishra.
3. In Search of the Real China: Outsiders Still See what They Want to See--John Pomfret.
4. Border Battle: the Ugly Legacy of the Mexican-American War--Enrique Krauze.
5. The Case for International Law: a Response to "The War of Law"--Harold Hongju Koh and Michael Doyle.
6. How to Copy Right: is Piracy Productive?--Steven Tepp, Kal Raustiala and Christopher Sprigman.
Farrell, Henry - Personal Name
Calomiris, Charles W. - Personal Name
Haber, Stephen H. - Personal Name
Fernandez, Jose W. - Personal Name
Sielen, Alan B. - Personal Name
Hastings, Max - Personal Name
Mishra, Pankaj - Personal Name
Pomfret, John - Personal Name
Krauze, Enrique - Personal Name
Koh, Harold Hongju - Personal Name
Doyle, Michael - Personal Name
Greenspan, Alan - Personal Name
Rid, Thomas - Personal Name
Raustiala, Kal - Personal Name
Sprigman, Christopher - Personal Name
Bhagwati, Jagdish - Personal Name
Rivera-Batiz, Francisco - Personal Name
Meyer, Henning - Personal Name
Finnemore, Martha - Personal Name
Garrett, Laurie - Personal Name
Noble, Ronald K. - Personal Name
Williams, Cindy - Personal Name
Leffler, Melvyn P. - Personal Name
Tepp, Steven - Personal Name
Calomiris, Charles W. - Personal Name
Haber, Stephen H. - Personal Name
Fernandez, Jose W. - Personal Name
Sielen, Alan B. - Personal Name
Hastings, Max - Personal Name
Mishra, Pankaj - Personal Name
Pomfret, John - Personal Name
Krauze, Enrique - Personal Name
Koh, Harold Hongju - Personal Name
Doyle, Michael - Personal Name
Greenspan, Alan - Personal Name
Rid, Thomas - Personal Name
Raustiala, Kal - Personal Name
Sprigman, Christopher - Personal Name
Bhagwati, Jagdish - Personal Name
Rivera-Batiz, Francisco - Personal Name
Meyer, Henning - Personal Name
Finnemore, Martha - Personal Name
Garrett, Laurie - Personal Name
Noble, Ronald K. - Personal Name
Williams, Cindy - Personal Name
Leffler, Melvyn P. - Personal Name
Tepp, Steven - Personal Name
November/December 2013, Volume 92 Number 6
Jurnal Foreign Affairs 14x323
0015-7120
Foreign Affairs
Jurnal
Inggris
Council on Foreign Relations
2013
Canada
196 hlm
Box No. 9 M (Jurnal Internasional)
LOADING LIST...
LOADING LIST...